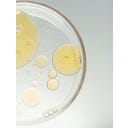
MERME Berlin Glowing Guard Face Oil - 30 ml

MERME Berlin Glowing Guard Face Oil, 30 ml
Gesichtsöl für eine zeitlose Ausstrahlung
€ 32,26
(€ 1.075,33 / l, inkl. 21% MwSt.
Eigenschaften und Vorteile
- Für alle Hauttypen - auch sensible
- Fördert den Regenerationsprozess
- Festigend & ausgleichend
- Reich an Antioxidantien
- Stärkt die Hautbarriere
-
 Vegan
Vegan -
 Tierversuchsfrei
Tierversuchsfrei
Beschreibung
Das Glowing Guard Face Oil von MERME Berlin schenkt deinem Teint eine neue Lebendigkeit und unterstützt die natürliche Regeneration deiner Haut. Durch die Kombination aus hochwertigem Bio-Hagebuttenöl und innovativer Wissenschaft bringt dieses Gesichtsöl deine Haut zum Strahlen und versorgt sie intensiv mit wertvollen Fettsäuren. Mit dem patentierten Inhaltsstoff Renovage™ verfeinerst du dein Hautbild sichtbar, milderst feine Linien und freust dich über ein festeres, ebenmäßigeres Erscheinungsbild. Für den Schutz gegen äußere Umwelteinflüsse sorgt Astaxanthin, das als eines der besten Antioxidantien gilt und deine Hautbarriere stärkt. Schon wenige Tropfen genügen, um Anzeichen vorzeitiger Hautalterung entgegenzutreten und dir ein seidiges, revitalisiertes Hautgefühl zu verleihen. Gönn dir dieses luxuriöse Treatment für einen Teint, der von innen heraus leuchtet.
Anwendung: Einen halben Pumpstoß auf die feuchte Haut auftragen – als letzten Schritt der abendlichen Pflegeroutine, nach Serum und Feuchtigkeitspflege.
Cosmeterie-Tipp: Seren immer auf angefeuchteter Haut anwenden – das fördert ihre Aufnahme in die Haut und verstärkt den Effekt deutlich.
| Art.-Nr.: | MER-4262496430075 |
|---|---|
| Inhalt: | 30 ml |
| EAN: | 4262496430075 |
| Hersteller-Nr.: | 4262496430075 |
| Marke: | MERME Berlin |
| Produktart: | Öle |
| Hauttyp: | Für jeden Hauttyp, Normale Haut, Mischhaut, Trockene Haut, Ölige Haut, Reife Haut, Sensible Haut, Unreine Haut |
| Eigenschaften: | Vegan, Tierversuchsfrei, Anti-Aging, antioxidant |
| Anwendungsgebiet: | Gesicht |
| Speziell für: | Frauen, Männer |
Inhaltsstoffe (INCI)
Rosa Canina Seed Oil, Dicaprylyl Carbonate, Caprylic/Capric Triglyceride, Tocopherol (Vitamin E), Teprenone, Helianthus Annus (Sunflower) Seed Oil, Astaxanthin